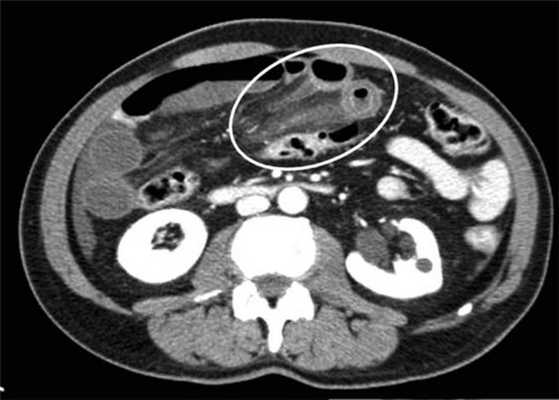

Рентгенограмма, КТ при завороте тонкой кишки
Добавил пользователь Дмитрий К. Обновлено: 23.12.2025
Рентгенограмма, КТ при завороте тонкой кишки
Мальротация кишечника (нонротация) у мужчины 39 лет.
(а, б) Тощая кишка — прямое продолжение двенадцатиперстной (стрелка, а), отсутствуют нормальные 3-й и 4-й сегменты двенадцатиперстной кишки, а также двенадцатиперстно-тощекишечный переход (звездочка, б).
(в, г) Петли тонкой кишки (прямые стрелки) лежат в левой половине брюшной полости, а ободочная кишка (изогнутые стрелки) — в правой половине. Заворот средней кишки у мальчика 11 лет.
(а) При КТ с контрастированием в аксиальной проекции выявлена транспозиция верхней брыжеечной артерии (указатель) и вены (стрелка).
(б, в) На более низких уровнях при КТ в аксиальной проекции выявлен симптом «водоворота» (стрелка), представляющий собой перекручивание верхней брыжеечной вены и ее ветвей, брыжеечного жира и петель кишки вокруг верхней брыжеечной артерии по часовой стрелке.
(г, д) На рентгенограммах выявлен симптом «штопора» — спиральная конфигурация 4-го отдела двенадцатиперстной кишки и проксимальной части тощей кишки.
Перекручивание тонкой кишки, приводящее к ее завороту, может быть вызвано различными причинами, такими как врожденная мальротация средней кишки, анатомические аномалии, воспалительный процесс и опухоли. Врожденный заворот кишечника обычно обнаруживают в первые месяцы жизни, он характеризуется патогномоничными визуализационными проявлениями, включающими симптом «штопора» и симптом «водоворота».
а) Определение и патогенез. Заворот тонкой кишки — патология, при которой происходит перекручивание тонкой кишки и ее брыжейки. Выделяют множество причин, лежащих в основе этой патологии, включая спаечный процесс, дефекты строения брыжейки и сальника, беременность, дивертикул Меккеля, опухоли, осложнения операций на брюшной полости и врожденная мальротация кишечника.
Врожденная мальротация кишечника обусловлена нарушением нормальной ротации первичной кишки в направлении против часовой стрелки. Среди широкого разнообразия вариантов мальротации в клинической практике наиболее часто встречают полное отсутствие ротации (нонротация). При этом состоянии тощая кишка служит прямым продолжением двенадцатиперстной, при этом отсутствуют 3-й и 4-й сегменты двенадцатиперстной кишки и двенадцатиперстно-тощекишечный переход. Петли тонкой кишки лежат в левой половине брюшной полости, а ободочная кишка — в правой половине. При завороте средней кишки ножка брыжейки сужена, а двенадцатиперстно-тощекишечный переход (местонахождение связки Трейтца) чаще расположен низко, по правую сторону от средней линии. Такие условия приводят к перекручиванию неправильно фиксированной тонкой кишки, а верхние брыжеечные артерия и вена располагаются в короткой и суженной ножке брыжейки.
В большинстве случаев заворот средней кишки диагностируют в течение первого месяца жизни, а приблизительно в половине случаев — в течение первой недели. Клинический признак заворота средней кишки у младенцев — рвота желчью. У взрослых заворот тонкой кишки вызван скорее приобретенными анатомическими предрасполагающими факторами, чем врожденной мальротацией кишечника, и его часто диагностируют на основании клинических признаков, характерных для кишечной непроходимости.
б) Лучевая диагностика заворота тонкой кишки. При стандартной рентгенографии чаще выявляют неспецифические признаки, и она редко бывает информативной в диагностике. Симптом «штопора», известный как диагностический признак заворота средней кишки, отображает спиральную конфигурацию 4-го сегмента двенадцатиперстной кишки и проксимальной части тощей кишки, классически выявляемую при рентгенографии у детей, особенно у младенцев. Его можно визуализировать в переднезадней и боковой проекциях.
Ультрасонография (УС) информативна при патологическом перекручивании верхних брыжеечных артерии и вены (симптом «водоворота»), выявляемом при цветном допплеровском картировании. Однако зависимость от мастерства исследователя, а также газ в тонкой кишке, мешающий исследованию верхних брыжеечных сосудов, часто ограничивают диагностическую пользу. КТ стала важным методом визуализационной диагностики, особенно при завороте тонкой кишки у взрослых. Как и при УС, характерным признаком при КТ служит симптом «водоворота», который возникает в результате перекручивания верхней брыжеечной вены и ее ветвей, брыжеечного жира, кишки и ветвей верхней брыжеечной артерии вокруг самой верхней брыжеечной артерии, чаще по часовой стрелке.
Также выявляют эктопию основной части петель тонкой кишки и патологическое расположение связки Трейтца.
1. Заворот тонкой кишки — состояние, при котором происходит перекручивание тонкой кишки и ее брыжейки.
2. При завороте средней кишки определяют характерные признаки, такие как симптом «штопора» (спиральная конфигурация дистальной части двенадцатиперстной кишки и проксимальной части тощей кишки), выявляемый при рентгенографии, и симптом «водоворота» — перекручивание верхней брыжеечной вены, брыжеечного жира и кишки вокруг верхней брыжеечной артерии, выявляемый при КТ с контрастированием.
Рентгенограмма, КТ при мальротации кишечника
а) Определение:
• Нарушение поворота кишечника вследствие задержки ротации и фиксации во время внутриутробного развития
б) Визуализация:
1. Общая характеристика:
• Лучший диагностический критерий:
о Обнаружение тонкой кишки в правой половине брюшной полости, а ободочной кишки - в левой
• Другие общие признаки:
о Множество вариаций и классификаций:
- Полное отсутствие поворота:
Тощая кишка расположена справа от позвоночного столба, подвздошная кишка находится слева от позвоночного столба или в тазу
- «Классическая» мальротация:
Слепая кишка располагается по средней линии или слева от нее
Положение фиксируется тяжами, протягивающимися от нижней поверхности печени (тяжами Ледда)
Тяжи Ледда проходят около двенадцатиперстной кишки и могут обусловливать ее обструкцию

(Слева) На аксиальной КТ с контрастным усилением, выполненной мужчине 27 лет, у которого появилась боль и рвота, определяется, что тонкая кишка целиком, включая двенадцатиперстную кишку, располагается справа от средней линии. Слепая кишка расположена центрально, а ободочная кишка — справа от средней линии.
(Справа) На рентгенограмме, полученной при рентгеноскопии верхних отделов ЖКТ у этого же пациента, определяется частичная обструкция на уровне дистальных отделов двенадцатиперстной кишки, которая не пересекает среднюю линию, но имеет своеобразный вид, напоминающий букву Z или «штопор». На операции подтвердилась мальротация и обструкция двенадцатиперстной кишки, обусловленная тяжами (Ледда).
2. Рентгенография при мальротации кишечника:
• Рентгенография:
о Симптом «двойного пузыря»: растяжение желудка и двенадцатиперстной кишки, в то время как остальные отделы тонкой кишки содержат малое количество газа
• Рентгеноскопия с бариевой взвесью:
о Отсутствие поворота: тонкая кишка находится в брюшной полости справа, ободочная кишка-слева
о Незавершенный поворот: слепая кишка ниже привратника
о Просвет двенадцатиперстной кишки, заполненный контрастом резко обрывается либо имеет вид «штопора»
3. КТ при мальротации кишечника:
• Позволяет оценить расположение всех отделов кишечника
• Верхняя брыжеечная вена (ВБВ) занимает более вентральное положение либо находится слева от верхней брыжеечной артерии (ВБА):
о Заворот центральной части пищеварительной трубки характеризуется симптомом «водоворота» или «вихря», который формируется при скручивании брыжеечных сосудов и кишки
4. Рекомендации по визуализации:
• Лучший метод диагностики:
о Рентгеноскопия верхних отделов ЖКТ с исследованием пассажа бариевой взвеси по тонкой кишке:
- Отсутствие патологических изменений при «бариевой клизме» не исключает ни мальротацию, ни заворот
о КТ позволяет обнаружить врожденные аномалии и осложнения

(Слева) На аксиальной КТ, выполненной женщине 4 7 лет с жалобами на боль, определяется, что верхняя брыжеечная артерия и вена находятся в положении, обратном типичному, а тонкая кишка целиком расположена в брюшной полости с правой стороны. Определяется утолщение стенки тощей кишки и ограниченный асцит, а также расширение просвета кишки.
(Справа) На аксиальной КТ с контрастным усилением у этой же пациентки визуализируются другие сегменты тощей кишки с утолщенной стенкой. Мальротация подтвердилась на операции наряду с ишемическими изменениями тощей кишки, которая была пережата из-за спаек.
в) Дифференциальная диагностика мальротации кишечника:
1. Парадуоденальная грыжа:
• Расширенные петли проксимальных отделов тонкой кишки в брюшинном мешке между поджелудочной железой и желудком
• Брыжеечные сосуды переполнены кровью, но взаимное отношение ВБА и ВБВ не нарушено
г) Патология. Общая характеристика:
• Сопутствующие патологические изменения:
о Омфалоцеле, гастрошизис, диафрагмальная грыжа
о Аспления, синдром полисплении, стеноз двенадцатиперстной кишки/атрезия, аннулярная поджелудочная железа, агенезия дорсальной части поджелудочной железы, болезнь Гиршпрунга
о Предуоденальная воротная вена, аномалии развития нижней полой вены
• Нормальный эмбриогенез:
о 6-10 неделя гестации:
- Двенадцатиперстно-тощекишечная петля совершает поворот на 180° против часовой стрелки, располагаясь на завершающем этапе позади ВБА
- Петля, образующая слепую и ободочную кишку, совершает поворот на 90° против часовой стрелки, располагаясь в итоге с левой стороны ВБА
о 10 неделя гестации: центральная часть пищеварительной трубки (средняя кишка) возвращается в брюшную полость:
- Двенадцатиперстно-тощекишечная петля совершает дополнительный поворот на 90° против часовой стрелки, занимая положение слева от позвоночного столба на уровне привратника; тощая кишка располагается в левом верхнем квадранте, а подвздошная в правом нижнем квадранте
- Петля, образующая слепую и ободочную кишку, дополнительно совершает поворот на 180° против часовой стрелки, в результате чего слепая кишка располагается в правом нижнем квадранте
о Широкое основание брыжейки (от левого верхнего до правого нижнего квадранта)
о Кишечник фиксируется в области основания слепой кишки, путем прикрепления связки Трейца к двенадцатиперстно-тощекишечной петле
• Возможны многочисленные варианты и комбинации
д) Клинические особенности:
1. Проявления мальротации кишечника:
• Наиболее частые признаки/симптомы:
о «Острый живот», увеличение живота
о Постоянная рвота, нарушение развития
2. Демография:
• Возраст:
о Вплоть до 40% случаев диагноз устанавливается в первую неделю жизни, в 50% на первом месяце, в 75% к первому году, в 25% после первого года
о В некоторых случаях заворот или обструкция возникают у детей старшего возраста либо у взрослых
• Пол:
о В целом мальротации встречаются одинаково часто у мужчин и у женщин; в возрасте до одного года соотношение мальротаций у мужчин и женщин составляет 2:1
• Эпидемиология:
о У одного из 500 живых новорожденных в США
3. Течение и прогноз:
• Осложнения: обструкция, заворот, тяжи Ледда
• Прогноз при своевременном лечении благоприятный:
о Может прогрессировать вплоть до нарушения кровообращения, ишемии, инфаркта
4. Лечение мальротации кишечника:
• Операция Ледда: устранение заворота; выделение кишечника из тяжей брыжейки, перемещение тонкой кишки вправо, ободочной кишки-влево; аппендэктомия
е) Диагностическая памятка:
1. Следует учесть:
• Как правило, проявления возникают в первые месяцы жизни
о У взрослых может возникать заворот и различные осложнения
2. Советы по интерпретации изображений:
• Изменения положения ВБА и ВБВ на противоположное
ж) Список использованной литературы:
1. Pathak N et al: Should gut malrotation be suspected in adolescents and young adults presenting with failure to thrive? Trap Gastroenterol. 34(3): 184-5, 2013
Заворот кишок (K56.2)
Примечание
В данную подрубрику включены:
- странгуляция ободочной или тонкой кишки;
Из данной подрубрики исключены:
- "Непроходимость двенадцатиперстной кишки" - K31.5
- "Врожденные аномалии фиксации кишечника" - Q43.3
- "Другая уточненная непроходимость кишечника у новорожденного" - P76.8
- "Непроходимость кишечника у новорожденного неуточненная" - P76.9

Автоматизация клиники: быстро и недорого!
- Подключено 300 клиник из 4 стран
- 800 RUB / 4500 KZT / 27 BYN - 1 рабочее место в месяц

Автоматизация клиники: быстро и недорого!
- Подключено 300 клиник из 4 стран
- 1 место - 800 RUB / 4500 KZT / 27 BYN в месяц
Мне интересно! Свяжитесь со мной
13-15 октября, Алматы, "Атакент"
600 брендов, более 150 компаний-участников из 20 стран.
Новинки рынка стоматологии. Цены от производителей
Классификация
Этиология и патогенез
Возникновение заворота в значительной степени связано со следующими факторами:
- состояние брыжейки и особенности ее прикрепления;
- наличие рубцовых изменений, которые обуславливают сближение между собой кишечных петель и удлинение участка кишки и брыжейки вследствие застоя и растяжения;
- фиксация петель кишечника и брыжейки спайками.
Поворот петли происходит вокруг оси брыжейки и при ее достаточной длине. Степень перекрута различна - от 90° до одного-двух полных оборотов. Чем сильнее перекручивание, тем больше нарушаются проходимость петли и ее питание.
Способствующие завороту кишок факторы:
- повышение внутрибрюшного давления при физическом напряжении (поднятие тяжестей);
- усиление перистальтики при переполнении кишечника неудобоваримой пищей в больших объемах, особенно после длительного голодания;
- запоры.
Наиболее часто встречаются завороты тонкой, сигмовидной и слепой кишок.
Тонкий кишечник
Практически все завороты тонкой кишки связаны с врожденными аномалиями. Основная из не связанных с врожденными аномалиями причин - приобретенные спайки брюшной полости.
Заворот тонкой кишки чаще происходит по ходу часовой стрелки. Длина вовлеченных в процесс кишечных петель различна. Возможен и тотальный заворот тонкой кишки.
- спайки;
- беременность;
- объемные образования в малом тазу;
- состояния после оперативного вмешательства на кишечнике;
- применение препаратов, влияющих на моторику кишечника.
Заворот кишок может развиваться в любой части толстой кишки. Наиболее часто развивается в сигмовидной кишке из-за особенностей анатомии брыжейки. Реже заворот кишок встречается в правом отделе толстой кишки и терминальном отделе подвздошной кишки или только в слепой кишке. В редких случаях может развиться заворот поперечно-ободочной кишки или толстой кишки в области селезеночного изгиба.
Полный заворот приводит к развитию замкнутой обструкции пострадавших сегментов кишечника. Увеличение дилатации петли кишечника вызывает нарушения кровоснабжения кишечника. В конечном итоге все это приводит к ишемии, гангрене и перфорации кишечной стенки.
Эпидемиология
Возраст: преимущественно зрелый и пожилой
Признак распространенности: Распространено
Соотношение полов(м/ж): 2
Локализация. Наиболее распространены завороты толстого кишечника:
- сигмовидной кишки - 80%;
- слепой кишки - 15%;
- поперечно-ободочной кишки - 3%;
- заворот в области селезеночного изгиба - 2%.
Возраст
Заворот сигмовидной кишки характерен для людей зрелого и пожилого возраста (средний возраст - 60 лет). Заболеваемость увеличивается с возрастом.
Заворот слепой кишки развивается в более молодом возрасте. Средний возраст возникновения - 50 лет. В отдельных регионах средний возраст возникновения заболевания значительно моложе (например, в Индии - 33 года).
В детском возрасте заворот толстого кишечника и слепой кишки является редкостью. Преобладающими в детском возрасте являются завороты тонкого кишечника, связанные с врожденной патологией и рассматривающиеся в отдельной подрубрике. Приобретенные завороты кишечника у детей считаются редкостью.
Пол. В разных возрастных группах и разных регионах соотношение полов различно. По усредненным оценкам преобладают мужчины, однако заворот слепой кишки встречается немного чаще у женщин.
Раса. Данные противоречивы. По общему мнению, лица африканской расы болеют в 2 раза чаще.
Другие условия
После спаек, заворот сигмовидной кишки является второй наиболее распространенной причиной непроходимости кишечника во время беременности (25-44% всех случаев). Предполагается, что во время беременности увеличенная матка может смещать сигмовидную кишку, что иногда приводит к скручиванию толстой кишки. В результате большинство (75%) случаев заворота у беременных происходит в течение третьего триместра.
Пациенты домов престарелых и психоневрологических клиник составляют значительную долю пациентов с заворотом толстого кишечника.
Факторы и группы риска
Заворот тонкой кишки (как правило, ассоциирован с врожденной патологией):
- врожденные аномалии развития;
- спаечные процессы в брюшной полости;
- внутренние грыжи брюшной полости
Заворот слепой кишки (преимущественно ассоциирован с врожденными аномалиями):
- аномально удлиненная брыжейка;
- хирургические операции на слепой кишке с ее мобилизацией;
- аппендицит с образованием спаек;
- колоноскопия Колоноскопия - метод исследования внутренней поверхности толстой кишки, основанный на ее осмотре с помощью колоноскопа.
;
- объемные образования органов малого таза и брюшной полости.
Клиническая картина
Клинические критерии диагностики
рвота; вздутие живота; запор; ассиметрия живота; каловая рвота; отсутствие симптомов раздражения брюшины; пальпируемое образование в проекции кишечника; шум плеска; тимпанит при перкуссии живота; дегидратация; тахикардия; боль в животе; усиление перистальтики
Cимптомы, течение
Типично острое начало. Появляется интенсивная боль в брюшной полости. Боль может иметь различную локализацию: эпигастральная или пупочная область, правая половина, нижние отделы живота.
Вслед за болью возникает рефлекторная рвота съеденной накануне пищей. Затем рвота становится частой и обильной, рвотные массы представлены застойным кишечным содержимым. На поздних стадиях заворота рвота приобретает каловый характер.
При тонкокишечном завороте всегда присутствует задержка стула и газов. В некоторых случаях в первые часы заболевания может наблюдаться акт дефекации за счет содержимого дистального отдела кишечника.
Больные находятся в тяжелом состоянии, которое прогрессивно ухудшается. Язык сухой и обложеный налетом грязного цвета.
При пальпации в начале заворота живот безболезнен и не вздут. У худощавых больных иногда удается прощупать узловатый конгломерат петель кишечника.
Заворот сигмовидной кишки
1. Остро протекающая форма:
- внезапная интенсивная схваткообразная боль с локализацией в левой половине живота;
- рвота;
- нередко - коллапс;
- быстрое развитие некроза кишечных петель с нарастанием перитонита.
2. Подостро прогрессирующая форма. Имеет постепенное начало и более легкое течение. Больные с данной формой поступают в больницу спустя 3-4 дня после появления симптомов. Как правило, в анамнезе у 50% пациентов уже наблюдались подобные приступы боли. Рвота возникает поздно. Живот вздут. При перкусии выявляется тимпанит Тимпанит (перкуторный звук тимпанический) - громкий, средней высоты или высокий перкуторный звук, возникающий при перкуссии над полым органом или полостью, содержащей воздух
. Ампула прямой кишки пуста и расширена.
Наряду с общими симптомами кишечной непроходимости, при завороте сигмовидной кишки присутствуют следующие типичные признаки:
При завороте слепой кишки длительность периода от возникновения симптомов до поступления в больницу может колебаться от 2 часов до 10 дней, (в среднем 2 дня).
Примечание. При любом виде заворота симптоматология, особенно в начале заболевания, зависит от быстроты наступления заворота.
Диагностика
Визуализация играет решающую роль в диагностике и дифференциальной диагностике заворота кишок.
1. Обзорная рентгенография.
1.1 Заворот сигмовидной кишки. На обзорной рентгенограмме брюшной полости выявляют резко увеличенную в объеме сигмовидную кишку, доходящую до диафрагмы, с двумя уровнями жидкости: одним в проксимальном конце непроходимой кишки, другим - в дистальном.
2.1 Заворот сигмовидной кишки. Место заворота имеет вид "клюва" ("пикового туза"), над которым определяется значительно расширенная петля сигмы. При ориентации “клюва” в правую сторону присутствует заворот по ходу часовой стрелки, влево - в обратном направлении.
2.2 Заворот слепой кишки. Во время ирригографии барий проходит только до середины восходящей ободочной кишки.
3. Оральное контрастирование (применяется только при подозрении на непроходимость тонкого кишечника):
- препятствие прохождению контраста;
- раздувшиеся петли тонкого кишечника;
- понижение наполнения толстого кишечника.
4. Компьютерная томография - "золотой стандарт" диагностики. Исследование особенно полезно при завороте слепой и тонкой кишок. При завороте возможно выявление специфического признака "знак бури" (спираль), расширение кишки, отек брыжейки, утолщение стенки кишки.
Диагностика заворота у беременных
При появлении болей в верхней части живота у беременных (вне зависимости от срока беременности) рекомендуется начинать обследование с УЗИ. При завороте, несмотря на затрудненное исследование газосодержащих органов, УЗИ может выявить раздутые петли кишечника, выпот в брюшной полости и др. признаки заболевания.
Диагностическая лапароскопия - высокоинформативный метод диагностики при кишечной непроходимости в I триместре беременности и в послеродовом периоде. Начиная со II триместра, использование метода затруднено вследствие увеличенных размеров матки и негативного влияния наркотических средств на плод.
Проведение колоноскопии нежелательно из-за возможного развития угрозы прерывания беременности.
Рентгенологические методы исследования противопоказаны при беременности и могут проводиться только в случае крайней необходимости, при подозрении на острую кишечную непроходимость и сроке беременности больше 13 недель (обзорная рентгенография брюшной полости).
Лабораторная диагностика
Не существует специфических лабораторных тестов, подтверждающих диагноз заворота кишок. Тем не менее надлежащие анализы должны быть выполнены для диагностики осложнений (некроз кишечника) и дифференциальной диагностики.
1. Общий анализ крови:
- умеренный лейкоцитоз;
- повышение СОЭ.
Значительное повышение этих показателей указывает на некроз кишечника. Повышение гематокрита может быть связано с рвотой.
3. Печеночные пробы: амилаза и липаза, как правило, в норме.
4. Анализ кала: иногда выявляется примесь крови в стуле (признак некроза слизистой).
Дифференциальный диагноз
Заворот тонкой кишки, если он не связан со спайками брюшной полости и опухолями, почти всегда связан с аномалиями развития. Дополнительно тонкокишечную непроходимость могут вызвать дивертикулы , опухоль, камни тонкого кишечника, спайки.
Заворот сигмовидной кишки. Дифференциальный диагноз включает рак толстой кишки, дивертикулит, брыжеечную ишемию и другие виды непроходимости кишечника.
Заворот слепой кишки обычно встречается в молодом возрасте и поэтому наиболее часто его приходится отличать от аппендицита, разрыва кисты яичника, инфекции мочевыводящих путей, дивертикулита, воспалительных заболеваний кишечника и непроходимости кишечника другой этиологии.
Решающую роль в дифференциальной диагностике, как и в установке диагноза, играют методы визуализации.
Осложнения
Прочие осложнения при хронической, неполной непроходимости:
- кисты брыжейки и хилезный асцит;
- спайки и стенозы кишечника.
Лечение
4. Контроль сопутствующей патологии.
5. Поскольку давление на нижнюю полую вену может привести к нарушению венозного возврата, пациент должен находиться в положении на левом боку (для улучшения венозного возврата).
6. Катетер Фолея для контроля диуреза .
При завороте тонкой кишки показано только хирургическое вмешательство – расправление заворота.
Если перитонит отсутствует, нежизнеспособные кишечные петли резецируются и формируется межкишечный анастомоз .
При наличии перитонита накладывается двуствольная илеостома с восстановлением целостности кишечника через 2-3 месяца.
Показания к хирургическому вмешательству:
- острая форма заворота сигмовидной кишки;
- неэффективность консервативных мероприятий при подостро прогрессирующей форме заворота.
При жизнеспособности сигмы применяются паллиативные и радикальные операции.
Паллиативные вмешательства: расправление заворота, реторсия в сочетании с мезосигмопликацией или сигмопексией.
Сигмопексии:
- подшивание кишки к париетальной брюшине;
- фиксация брыжейки кишки к париетальной брюшине;
- помещение сигмовидной кишки под выкроенный лоскут париетальной брюшины или в карман в предбрюшинном пространстве.
Данные операции характеризуются высоким процентом рецидивов.
Радикальные операции предполагают выполнение резекции сигмовидной кишки с первичным анастомозом "конец в конец", "конец в бок".
Резекция сигмы с первичным анастомозом редко применяется в случае заворота сигмы, осложненного гангреной. Это связано с высокой опасностью несостоятельности швов вследствие имеющегося нарушения микроциркуляции в стенке кишки.
Наиболее часто применяется операция Гартмана: резекция нежизнеспособного участка сигмы с ушиванием ее дистального конца и выведением проксимального противоестественного заднепроходного отверстия. После улучшения состояния больного (в среднем через 3 месяца) на втором этапе операции кишечный свищ закрывается.
Послеоперационное лечение:
- инфузионная терапия;
- антибактериальная терапия.
Возможные послеоперационные осложнения:

Схема выбора метода лечения при завороте кишки
Прогноз
Рецидивы. Частота рецидивов после эндоскопической декомпресии составляет до 50%.
Госпитализация
Профилактика
1. Профилактика запоров:
- контроль применения психотропных, слабительных и иных фармакологических препаратов, влияющих на моторику желудочно-кишечного тракта;
- ограничение в питании чрезмерного количества грубой клетчатки.
Тонкокишечная непроходимость
В настоящее время до 15% оперативных вмешательств пациентам, поступившим с симптомами острого живота, выполняются по поводу тонкокишечной непроходимости. В Европе до 60% случаев возникают по причине спаечной болезни, 20% из-за различных грыж, и около 15% обструкций связаны с неопластическими процессами. В США 50-75% случаев связаны со спайкообразованием, на втором месте идёт болезнь Крона и воспалительные энтериты, и на последнем месте онкология.



Современные подходы диагностики включают в себя УЗИ брюшной полости или рентгенографию в положении стоя- как первая линия визуализации. В последнее время наблюдается повышенная тенденция использования УЗ-метода, который, как считают некоторые авторы, может заменить классическую рентгенографию. УЗИ позволяет корректно определить наличие тонкокишечной обструкции, при этом зачастую выявляет много рaзличной дополнительной диагностической информации, имеющей определяющее значение для лечебной тактики.
Основным методом окончательной, верифицированой диагностики непроходимости тонкой кишки на данный момент является СКТ/МДКТ с болюсным контрастным услением, являясь золотым стандартом визуализации.
По механизму возникновения острую тонкокишечную непроходимость подразделяют на:
- обтурация просвета
- сужения просвета
- компрессия извне
- блокада пассажа
- непроходимость толстой кишки
- странгулуация/заворот
- комплексный механизм.
Этииология и механизмы возникновения непроходимости тонкой кишки хорошо описаны в многих руководствах и монографиях, поэтому не буду дублировать эту широко доступную информацию.


Стеноз подвздошной кишки при болезни Крона
Рентгенография
B ранней стадии непроходимости на обзорных рентгенограммах в положении лёжа будут видны умеренно pаздутые петли тонкой кишки с небольшим содержанием воздуха. При съёмке в положении стоя или на левом боку определяются множественныe уровни газ-жидкость. Складки Керкринга на ранних стадиях видны, по мере прогрессирования обструкции петли растягиваются и складки смазываются. Иногда очень сложно отличить раздутые петли тонкой кишки от толстой.


Обзорная рентгенография живота в положении стоя

Обзорная рентгенография живота в положении лёжа
КТ визуализация при простой форме
Хирургическая классификация тонкокишечной непроходимости также является основой классификации, используемой в радиологии. Раличают три формы:
- простая/компенсированная форма
- декомпенсированная форма
- осложнённая форма.
-Расширенные петли тонкой кишки проксимальнее транзиторной зоны (зоны обструкции).
-Под транзиторной зоной надо понимать зонy кишки с очевидной разностью в диаметре просвета между расширенным проксимальным сегментом и местом сужения/обструкции. Визуализация этой зоны зависит от причины и механизма обструкции, а также от проекции расположения петли (аксиально, фронтально и т.д.). К сожалению, обнаружение этой зоны не всегда представляется возможным. При спаечном механизме или воспалении многими хорошо описан признак "птичьего клюва". При обструкции в результате алиментарного болюса транзиторная зона будет выглядеть как гетерогенное образование в просвете кишки без признаков контрастного усиления.
-Спавшиеся петли кишечника дистальнее уровня обструкции.
-Смешанный характер стаза содержимого кишечника в расширенных петлях. Некоторыми авторами описан "фекалоидный" тип стаза, описанный в литературе как "каловое содержимое тонкой кишки", в английской литературе-“small-bowel faeces sign”. Патогенез данного признака включает в себя много факторов:
замедление пассажа содержимого, нарушения механизмов абсорбции и секреции в тонкой кишке, рефлюкс из толстой кишки из-за недостаточности илео-цекального клапана, постановка желудочного зонда. Необходимо помнить, что этот признак неспецифичен при тонкокишечной непроходимости, его также можно определить на УЗИ и обзорной рентгенограмме брюшной полости.
-Нормальные неутолщённые стенки кишечника с гомогенным одинаковым контрастным усилением.
-В тощей кишке рисунок ворсинок слизистой (valvulae conniventes) тонкий, и он одинаково выглядят на всём протяжении.
-Отсутствие патологических изменений толстой кишки, толстая кишка как правило спавшаяся или содержит небольшое количество калового содержимого, распределённого по всему просвету.
-Отсутствие воспалительных изменений в брыжейке и внутрибрюшинном жире.
-Нормальная васкуляризация сосудов брыжейки.
-Отсутствие свободной жидкости в брюшной полости.


Различные КТ сканы при простой форме обструкции, cxематично изображены транзиторные зоны и спайки, которые как "хомут" или "удавка" как-бы душат петлю кишки.


Значение реконструкций в разных проекциях для определения уровня обструкции.

Обструкция просвета фитобезоаром.

Декомпенсированная форма
Определяются все признаки, описанные при простой форме, дополнительно появляются патологические изменения в брюшной полости:
-расширенные петли тонкой кишки проксимальнее транзиторной зоны (зоны обструкции);
-спавшиеся петли кишечника дистальнее уровня обструкции;
-нормальные не утолщённые стенки кишечника с гомогенным одинаковым контрастным усилением;
-свободная жидкость между расширенными петлями кишечника, зачастую в виде пикантной детали женского туалета-трусиков танга, поэтому в многих источниках описывается как признак "танга" (tanga sign);
-свободная жидкость в брыжеечных карманах;
-свободная жидкость в брюшной полости.


Примеры скопления жидкости между петлями кишечника (танга) и в карманах брыжейки при декомпенсированной форме.

Осложнённая форма (чаще всего в результате странгуляции)
Для странгуляции тонкой кишки характерны утолщение стенок кишечника, васкулярные нарушения и выраженные патологические изменения в брыжейке и в брюшной полости. Диагностические находки включают в себя:
-расширенные петли тонкой кишки проксимальнее транзиторной зоны (зоны обструкции);
-спавшиеся петли кишечника дистальнее уровня обструкции;
-транзиторная зона;
-смешанный характер стаза содержимого кишечника в расширенных петлях с преобладанием жидкостного компонента;
-утолщение стенки кишки циркулярного типа. Важно помнить, такой тип утолщения стенок тонкой кишки при непроходимости как правило связан с сосудистыми нарушениями;
-нарушение нормального контрастного усиления стенок кишки. Изменения варьируют от гиперконтрастирования до полного отсуствия контрастного усиления. Различные варианты этих изменений между описанными выше крайностями могут наблюдаться одновременно в разных сегментах тонкой кишки. Полное отсутствие усиления означает артериальный рефлекторный спазм и свидетельствует в пользу тяжести поражения;
-петля с утолщенными стенками теряет свою эластичность и становится ригидной, вытянутой;
-пристеночный пневматоз тонкой кишки, в особо тяжелых случаях появляются интрамуральные пузырьки газа;
-появление патологических плотностей в брыжейке в виде распространяющихся матовых инфильтратов и тяжистости за счет кровоизлияний в жировые ткани;
-застойные изменения сосудов брыжейки. Сначала диаметр сосудов увеличивается, но со временем наступает рефлекторный артериальный спазм, брыжейка будет выглядеть с обеднённой васкуляризацией. Сосуды сужены или с полностью коллабированным просветом;
-газ в просвете верхней брыжеечной вены;
-газ в просвете портальной вены;
-при заворотах нарушается нормальная сосудистая анатомия брыжейки. Сосуды как бы закручиваются вокруг оси заворота и тянут за собой измененный брыжеечный жир- по типу раковины улитки или торнадо. Для большей наглядности представьте себе кусок расправленной ткани на столе, которую вы прижали пальцем и начали закручивать не отрывая ваш палец от стола. На КТ сканах часто можно увидеть характерный признак конусовидной спирали (whirl sign);
-свободная жидкость в карманах брыжейки и в брюшной полости. Иногда жидкость может быть повышенной плотности за счет геморрагического компонента.

примеры странгуляционной осложнённой непроходимости с характерными изменениями в брыжейке, внутрибрюшинном жире, утолщением стенок тонкой кишки и нарушением контрастного усиления.


Закручивание сосуда при завороте
УЗД признаки тонкокишечной непроходимости
Основные УЗ-признаки при непроходмости- это визуализация расширенных петель тонкой кишки, сниженная перистальтика, свободная жидкость между петлями (танга) и в брюшной полости. Также УЗИ иногда позволяет обнаружить причину обструкции, например, опухоль, утолщение стенок терминального сегмента подвздошной кишки при болезни Крона и т.д. УЗИ может решить диагностическую дилемму при неоднозначных рентгенологических признаках на обзорной рентгенограмме брюшной полости. Лимит метода заключается в низкой специфичности при оценки состояния брыжейки, а также зависимость качества диагностики от конституции пациента и опыта оператора.
Тема непроходимости кишечника в результате инвагинации не будет освещена в даннoм обзоре, она хорошо описана в многих отечественных и зарубежных публикациях. Думаю, что все коллеги занимающиеся данной проблемой знают, что определяющее значение в диагностике инвагинации пренадлежит УЗ-диагностике. На нашем сайте ранее было размещено показательное наблюдние:


примеры сонограмм с расширенными петлями тонкой кишки


УЗИ позволяет прекрасно лоцировать свободную жидкость в брюшной полости
Паралитический илеус
Паралитическая или адинамическая непроходимость означает нарушение пассажа по кишечнику без наличия механической обструкции просвета в результате снижения или полного отсутствия тонуса кишки и перистальтики. Может поражаться как тонкая, так и толстая кишка. Вовлечение в процесс желудка отражает серьезность ситуации. При паралитическом илеусе наблюдаются комплексные радиологические симптомы. Ограничимся перечислением основных моментов, которые всегда визуализируются при данной патологии:
-расширение просвета кишки;
-стаз кишечника с преобладанием жидкостного компонента и уровнями воздуха;
-снижение тонуса и перистальтики.
Очень важно динамическое наблюдение за перечисленными признаками, что отдает пальму первенства УЗИ как наиболее адекватному и безопасному методу визуализации при адинамической непроходимости.
Заворот кишечника

array(6) < ["ID"]=>string(5) "30063" ["WIDTH"]=> int(620) ["HEIGHT"]=> int(510) ["SRC"]=> string(86) "/upload/sprint.editor/610/img-1658586165-8955-294-5c96c500e41f1d29e92a5a562a0b9c90.jpg" ["ORIGIN_SRC"]=> string(86) "/upload/sprint.editor/610/img-1658586165-8955-294-5c96c500e41f1d29e92a5a562a0b9c90.jpg" ["DESCRIPTION"]=> string(0) "" >
Кишечная непроходимость – это патологическое состояние, ведущее к нарушению пассажа пищевого комка по кишечнику, расстройству кровообращения, интоксикации организма, а при неблагоприятном исходе к омертвению и перфорации участков кишечной стенки и гибели человека.
Одна из причин непроходимости – заворот кишечника – ситуация, когда часть толстой или тонкой кишки перекручивается вокруг собственной оси или вокруг оси брыжейки. Места перекрута становятся зажимом не только для пищевой массы, но и для нервных волокон, кровеносных и лимфатических сосудов.
Причины заворота кишок и факторы риска
Чтобы произошел поворот, должны возникнуть нетипичные, форс-мажорные обстоятельства. Это могут быть внутренние и внешние причины:
- физические: травма живота, удар об воду, резкий поворот тела, вынужденная непривычная поза, сдавление, сотрясение, подъем тяжестей;
- пищевые: переедание, особенно после длительного голодания, употребление незнакомой экзотической пищи, большое количество труднопереваримой клетчатки в рационе, продолжительный голод;
- органические: спаечные процессы, пупочная грыжа, новообразования, нарушение иннервации кишечника вследствие поражения центральной нервной системы, беременность;
- химические: отравление свинцом или лекарственными препаратами.
При анализе данных о пациентах были выявлены факторы, увеличивающие вероятность возникновения перекручивания кишок:
- возраст старше 55 лет (заворот сигмовидной кишки часто возникает у пациентов старше 60 лет, ободочной и слепой кишки – после 50 лет);
- регулярные запоры или поносы;
- малоподвижный образ жизни;
- тяжелый физический труд;
- фанатичная приверженность различным системам голодания для похудения, нерегулярное питание;
- переедание, особенно перед сном.
Основные симптомы
Заворот кишечника – состояние опасное для здоровья и жизни, поэтому при первых же признаках недомогания следует обращаться за врачебной помощью.
Симптомы по степени их появления и нарастания:
острая, схваткообразная боль в животе
в течение суток боль становится постоянной и труднопереносимой, может дойти до состояния шока
асимметрия контуров живота, вздутие
тошнота,многократная рвота (может быть с желчью, а в тяжелых случаях с запахом или примесью кала)
слабость, бледность, низкое артериальное давление, учащенный пульс
головная боль, головокружение, возможно спутанное сознание (и другие признаки интоксикации)
обезвоживание (сухие и потрескавшиеся губы, вязкая слюна, тусклая кожа)
Патология развивается быстро и состояние больного стремительно ухудшается. Человек погибнет в течение 2–3 суток, если не будет оказана экстренная медицинская помощь.

Оставьте заявку и наши врачи ответят на все ваши вопросы!
Как развивается заболевание
При полном перекрытии просвета кишки пищевые массы и газы не могут выйти естественным путем. Кишечник сокращается, пытается продвинуть содержимое, но не может. Возникают острые приступообразные боли. Накапливается газ и продукты распада, отравляется нервная система. Зажатый участок кишки начинает раздуваться от брожения (отсюда постоянная сильная боль и визуальное увеличение живота). Нарушается кровоток и передача нервного импульса.
Прекращается перистальтика. Поскольку нет кровоснабжения, ткань не получает кислород и гибнет. Образуются зоны омертвения. Стенка кишечника разъедается, разрывается, и содержимое патологического очага – изливается в брюшную полость, нарушая внутреннее равновесие в брюшине и обсеменяя все органы бактериями, вызывая воспаление (перитонит).



Врач-хирург Юсуповской больницы проводит визуальный, мануальный и инструментальный осмотр, собирает анамнез и направляет на дальнейшее обследование.

array(6) < ["ID"]=>string(5) "30070" ["WIDTH"]=> int(620) ["HEIGHT"]=> int(480) ["SRC"]=> string(86) "/upload/sprint.editor/ab5/img-1658586783-9891-583-401ab96fbda1d27d061799d958010d0b.jpg" ["ORIGIN_SRC"]=> string(86) "/upload/sprint.editor/ab5/img-1658586783-9891-583-401ab96fbda1d27d061799d958010d0b.jpg" ["DESCRIPTION"]=> string(0) "" >
Подтвердить или опровергнуть кишечную непроходимость по причине заворота кишечника можно при помощи:
- рентген контрастного исследования с барием;
- ультразвуковой диагностики;
- эндоскопии;
- лапароскопии;
- лабораторной диагностики.
Специализированных лабораторных тестов нет, но общий анализ и биохимия крови могут показать глубину интоксикации и воспалительного процесса.
Поскольку состояние пациента при кишечной непроходимости быстро ухудшается, применяется только хирургическое лечение заворота кишок. Операция полостная, хирург вручную расправляет образовавшуюся петлю кишечника; в зависимости от стадии развития процесса иссекает зоны поражения или весь раздувшийся участок; возвращает функциональное состояние.
заворот кишок операция
Для успешного лечения и восстановления после операции врачами Юсуповской больницы применяется назоинтестинальный зонд. Он вводится во время операции, после всех основных хирургических манипуляций. Зонд пропускается через пищевод и желудок в оперированный отдел кишечника и находится там до восстановления иннервации, моторики и кровообращения, поддерживая правильное положение и свободный просвет кишки. Под наблюдением врача извлекается через 3–7 дней.
Медикаментозное лечение носит симптоматический характер: обезболивание, снятие спазмов и позывов к рвоте, восстановление водно-солевого баланса.
В терапевтических целях используются и сифонные клизмы.




Заворот кишок может повторяться, поэтому следует неукоснительно выполнять рекомендации лечащего врача, особенно на стадии реабилитации. Придерживаться назначенной диеты и физических нагрузок.
Любая внутрибрюшная операция может послужить причиной образования спаек. Поэтому, помимо соблюдения режима питания и активности, нужно периодически проходить профилактические медицинские осмотры и своевременно обращаться к врачу.
При завороте кишечника счет идет на часы, поэтому, чем раньше пациент обратиться за медицинской помощью, тем меньше необратимых процессов произойдет и легче будет устранить болезнь. Попытки прибегнуть к самолечению в этой ситуации бесполезны и опасны, они могут усугубить состояние и привести к смерти.
В Юсуповской больнице есть все возможности для проведения экстренной диагностики и лечения, а также для комфортного восстановления здоровья пациентов.
Читайте также:
